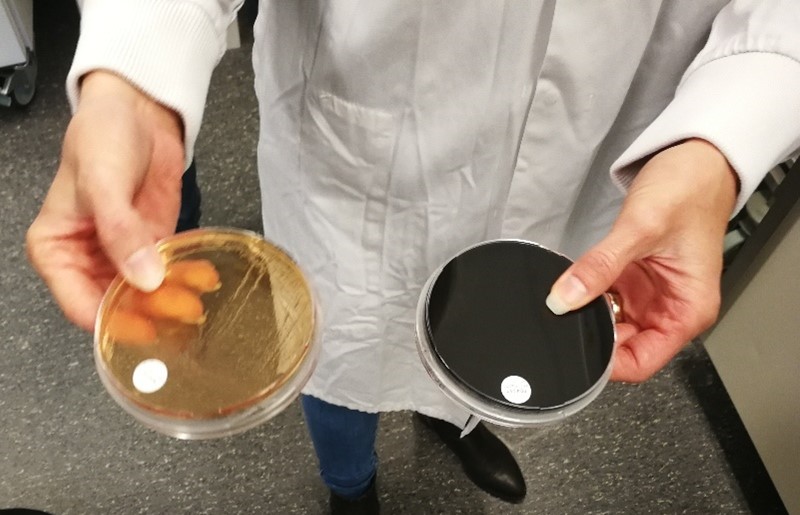

Насловна »
ПОСЕТА НАЦИОНАЛНИМ ЛАБОРАТОРИЈАМА КРАЉЕВИНЕ ХОЛАНДИЈЕ ЗА ФИТОСАНИТАРНА ИСПИТИВАЊА
На позив Министарства пољопривреде Краљевине Холандије уз активно учешће Амбасаде Холандије у Београду, а посебно Аташеа за пољопривреду господина Koen Van Ginneken и госпође Миле Мирковић, као резултат наставка заједничке сарадње у фитосанитарној области између две земље у периоду од 17. до 19. октобра 2022. године, организована је посета релевантним институцијама у Холандији. Делегацију су чинили представници Управе за заштиту биља, представници ДНРЛа, лабораторије чиниоци фитосанитарне контроле Републике Србије. Представници Дирекције за националне референтне лабораторије предвођени директором Гораном Зебићем, шефом фитосанитарне лабораторије за фитосанитарна испитивања и испитивања квалитета семена Александром Божић и аналитичарем за молекуларно билошка испитивања биљних патогена Маријом Миленковић посетили су три лабораторије за фитосанитарна испитивања, произођаче и складишта семенског кромпира Краљевине Холандије.
Првог дана организована је радна посета Naktuibouw, Roelofarendsveen, Холандској инспекцијској служба за хортикултуру која промовише и прати квалитет производа, процеса и производних ланаца у сектору хортикултуре. Главни фокус био је на анализи садног материјала, националног и међународног порекла.
Другог дана посетили смо Холандски институт за мониторинг вектора, инвазивне биљке и здравље биљака Netherlands Institute for Vectors, Invasive plants and Plant health (NIVIP) Wageningen, који је једна од чинилаца конзорцијума Европских референтних лабораторија за бактерије. др Maria Bergsma- Vlami, са својим сарадницима презентовала је активности рада NIVIP, као националне референтне лабораторије за бактерије, специјализована и одговорна је за одржавање стандарда за рутинска тестирања и обезбеђивање упутстава и подршке за званичне лабораторије у систему надзора за усвајање (међу)националних стандарда и протокола.
Дирекција за националне рефернтне лабораторије презентовала је свој рад и активности деловања у области фитосанитарне анализе, извршена је размена искуства и размотрена мишљења око продубљивања сарадње између лабораторија.
Након уводних састанака и обострано презентованих радних активности, извршена је непосредна размена знања и искустава у свакодневном лабораторијском раду у самим лабораторијама и стакленику NIVIPa, са посебним освртом на анализу Clavibacter michiganensis subps. sepedonicus у семенском кромпиру.
Посета произвођачима семенског кромпира са освртом на складиштење начин и услове чувања, калибрације, паковања, контроле и дистрибуције семенског кромпира.
Посета је завршена трећег дана, централној лабораторији за испитивање семенског кромпира у Краљевини Холандији, NAK лабораторији у Emmelordu.
На лицу места презентован је целокупан процес испитивања имунофлоресцентом методом која је тренутно главна скрининг метода за анализу у Краљевини Холандији, што је омогућило да се на лицу места размене искуства у области рада.
На завршном састанку представници Министарства пољопривреде шумарства и водопривреде Републике Србије и Министарства пољопривреде Краљевине Холандије, размотрили су резултате посете и договерене су даље активности за наставак сарадње у корист обе земље.
О посети и сарадњи две земље можете видети на:
https://www.agroberichtenbuitenland.nl/actueel/nieuws/2022/10/28/serbia-eu